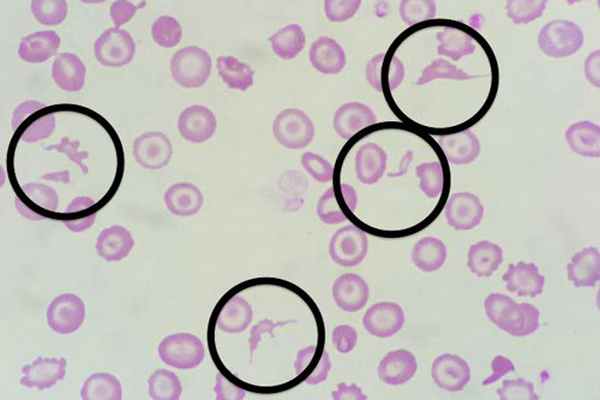

Анемия при миелофтизе
Добавил пользователь Валентин П. Обновлено: 15.12.2025
Anemia in cancer-bearing dogs and cats may arise through different mechanisms. Direct effects of growing tumors on surrounding tissues can cause acute or chronic blood loss that is often recognized in dogs with splenic hemangiosarcoma, animals with malignant epithelial mucosal tumors and end-stage tumors with hemorrhagic effusions. Immune-mediated hemolysis is sometimes recognized in patients with lymphoma and leukemia while non immune-mediated hemolysis may arise in dogs with splenic hemangiosarcoma (microangiopathic hemolysis) and haemophagocytic histiocytic sarcoma (phagocytosis), dogs and cats with lymphoma (with Heinz bodies formation). Decreased erythrocyte production occurs in patients with leukemia, bone marrow dissemination of hemic malignancies. Indirect mechanisms of anemia include anemia of inflammatory disease and nutritional deficit. Anemia is also an often complication of cancer treatment modalities. Recognition of anemia severity and its underling mechanisms is needed for optimal treatment of cancer-associated anemia.
Введение
Анемия является частой находкой у людей с онкологическими заболеваниями. Ее инцидентность у человека оценивается в широких пределах 30-70%, тогда как истинная частота встречаемости анемии у собак и кошек с опухолями не известна [1]. Как и у человека, наибольшая частота развития анемии отмечается у мелких домашних животных при наличии опухолей гематопоэтического происхождения (хронических и острых лейкозах, лимфомах, мастоцитомах, плазмаклеточных и гистиоцитарных опухолях), тогда как солидные опухоли реже сопровождаются анемией [2].
В ходе диагностики опухолей у мелких домашних животных выявление опухоль-ассоциированной анемии, определение ее характера, выраженности и возможных причин играет важную роль по нескольким причинам. Во-первых, наличие выраженной анемии может потребовать коррекции перед началом лечения, направленного непосредственного на онкологическое заболевание, поскольку многие методы терапии злокачественных опухолей (хирургическое лечение, цитотоксическая химиотерапия, лучевая терапия) сопровождаются дополнительной потерей эритрона. Во-вторых, анемия может является маркером некоторых злокачественных опухолей (например, лейкозов), а также маркером ответа данных опухолей на проводимую терапию. Таким образом, оценка динамики гематокрита/гемоглобина при проведении терапии может дать важную информацию об ответе на лечение. В-третьих, анемия является важным маркером неблагоприятного прогноза для ряда опухолей. Например, в исследовании Miller A.G. с соавт. (2009) было показано, что собак с лимфомой, сопровождающейся анемией, имели меньшую выживаемость при проведении лечения по сравнению с животными, имеющими нормальные показатели гематокрита [2].
Обзор данных литературы
Анемия у пациентов с онкологическими заболеваниями может возникать по различным причинам [3]:
· в результате непосредственного воздействия опухоли;
· в результате опосредованного влияния опухоли – как паранеопластический синдром;
· в ходе проведения противоопухолевого лечения.
Непосредственное воздействие опухоли может приводить к анемии по различным механизмам: 1) острая или хроническая кровопотеря; 2) гемолиз; 3) снижение продукции эритроцитов костным мозгом [3]. Так, наличие гемангиосарком селезенки – злокачественных опухолей эндотелия кровеносных сосудов – часто сопровождается разрывом органа с накоплением гемоабдомена (рис. 1А,Б). И, наоборот, среди самых частых причин развития геморрагического перитонеального выпота у собак является разрыв селезенки с гемангиосаркомой [4]. При этом собаки могут поступать в клинику с симптомами острого геморрагического шока. При разрыве гемангиосарком селезенки, а также печени, цитологическое исследование редко является диагностичным для выявления опухолевых клеток, а основная терапия включает хирургическое удаление селезенки/доли печени. Для корректировки анемии в данных случаях часто есть необходимость в проведении гемотрансфузий. Хроническая кровопотеря часто сопровождает эпителиальные опухоли слизистых оболочек – желудка и кишечника, носовых ходов (с развитием эпистаксиса), мочевого пузыря (с развитием геморрагического цистита), а также метастазирование любых злокачественных опухолей по серозным оболочкам с формированием геморрагических метастатических выпотных жидкостей (рис. 1В).
Рис. 1. А – гемоабдомен, развившийся у собаки в результате разрыва селезенки (аутопсия); Б – гемангиосаркома селезенки собаки – крупное сосудистое злокачественное новообразование, часто приводящее к гемоабдомену в результате разрыва органа; В – аутопсия кошки с метастазами фибросаркомы в легких, по плевре с формированием геморрагического плеврального выпота.Гемолиз у онкологических пациентов может развиваться по иммуно-опосредованным механизмам или в их отсутствие. Аутоиммунная гемолитическая анемия (АГА) развивается чаще всего при лейкозах и лимфомах у собак; у кошек лимфома, ассоциированная с вирусной лейкемией кошек также может сопровождаться АГА [5]. В данном случае диагностичным будет проведение теста Кумбса на наличие антиэритроцитарных антител. У пациентов с АГА часто отмечается аутоагглютинация, а при исследовании мазка крови у собак часто могут быть выявлены сфероциты (мелкие эритроциты без центральной зоны просветления) (рис. 2А). В данных случаях основная терапия будет направлена на иммносупрессию (преднизолон в дозировке 2-4 мг/кг в монотерапии и/или другие иммуносупрессанты) в течение длительного срока с постепенной отменой. Гемолиз в отсутствие иммуно-опосредованных механизмов часто отмечают при гемангиосаркомах селезенки в результате развития микроангиопатического гемолиза. При данной опухоли наличие большого сосудистого образования часто создает турбулентные потоки крови, проводящие к фрагментации эритроцитов с дальнейшим их внутрисосудистым гемолизом. В мазках крови в данном случае типично выявляют шистоциты (фрагментированные эритроциты) (рис. 2Б) [6]. Спленэктомия с возможной адъювантной химиотерапией (для профилактики развития гематогенных метастазов) показана у таких животных.Другой причиной гемолиза может быть оксидативное повреждение эритроцитов с развитием анемии с тельцами Гейнца (Хайнца), которое описано у собак и кошек с лимфомой. Описано, что у кошек анатомическая форма алиментарной лимфомы (с локализацией в желудочно-кишечном тракте) наиболее часто приводит к анемии с тельцами Гейнца (рис. 2В) [3].
Рис. 2. А – мазок крови со сфероцитами (мелкими эритроцитами без центральной зоны просветления), которые часто выявляют при аутоиммунной анемии; Б – шистоциты – фрагментированные эритроциты, которые можно обнаружить у собак с гемангиосаркомой селезенки при развитии микроангиопатического гемолиза; В – мазок крови от кошки с гемолитической анемией с формированием телец Гейнца (Хайнца), окраска метиленовым синим (тельца имеют базофильную окраску, располагаются вблизи мембраны наподобие «соска») (А-В, окраска по Романовскому, х1000).Редко встречающаяся опухоль селезенки у собак – гемофагоцитарная гистиоцитарная саркома (злокачественная пролиферация CD11d+/CD18+ макрофаги красной пульпы селезенки у собак) – сопровождается регенераторная гемолитическая анемия анемией умеренной или выраженной степени, возникающим в результате активного фагоцитоза эритроцитов опухолевыми клетками. В связи с тем, что опухоль не дает крупных очаговых образований, а сопровождается диффузной спленомегалией, ее часто клинически путают с аутоиммунной гемолитической анемией и тромбоцитопенией. Для диагностики опухоли показана тонкоигольная аспирационная биопсия из селезенки, которая имеет характерную цитологическую картину (рис. 3А). Основным лечением является спленэктомия, хотя прогноз заболевания даже при проведении хирургического лечения неблагоприятный в связи с высоким метастатическим потенциалом опухоли. По данным одного исследования средняя выживаемость собак с опухоль составляет около 7 недель (медиана – 4 недели) [7].И, наконец, к прямому воздействию опухолей на костной мозг со снижением продукции эритроцитов относится миелофтиз – замещение костно-мозговых пространств клетками, подавляющими пролиферацию нормальных гематопоэтических клеток. При миелофтизе, характерном для лейкозов, диссеминированных лимфом (рис. 3В), мастоцитом (рис. 3Б), гистиоцитарных сарком и множественных миелом, реже – карцином и сарком, типично наличие нерегенераторной нормоцитарной нормохромной анемии средней или сильной степени, часто в сочетании с тромбоцитопенией и лейкопенией [8]. При наличии таких изменений в клиническом анализе крови важнейшим этапом является оценка мазка венозной крови на наличие атипичных клеток (рис. 3Г). Для подтверждения миелофтиза необходимым также является цито- или гистологический анализ костного мозга (рис. 3Б,В).
Анемия при миелофтизе
Анемия при миелофтизе – нормоцитарная, нормохромная анемия, которая возникает при инфильтрации или замещении нормального костного мозга негемопоэтическими или аномальными клетками. Причины включают опухоли, гранулематозные заболевания, болезни накопления липидов и первичный миелофиброз. Также часто развивается фиброз костного мозга как вторичный процесс. Может развиваться спленомегалия. К характерным изменениям в периферической крови относятся анизоцитоз, пойкилоцитоз, избыточное количество клеток – предшественников эритропоэза и лейкопоэза. Диагноз обычно основан на результатах биопсии костного мозга. Применяются поддерживающая терапия и лечение основного заболевания.
Миелофтизная анемия развивается при инфильтрации костного мозга и замещении его негематопоэтическими или аномальными клетками, такими как опухолевые клетки, или при замещении костного мозга фиброзной тканью.
Описательная терминология, используемая при данном типе анемии, может показаться запутанной. Миелофиброз, который представляет собой замещение костного мозга фиброзной тканью, может быть
Первичным вследствие рака костного мозга. Первичный миелофиброз Первичный Миелофиброз Первичный миелофиброз (ПМФ) – это хроническое миелопролиферативное новообразование, которое характеризуется фиброзом костного мозга, спленомегалией и анемией с наличием ядросодержащих и каплевидных. Прочитайте дополнительные сведения является дефектом гемопоэтических стволовых клеток, при котором фиброз является результатом мутаций в генах JAK2 (Янус-киназа 2), CALR (кальретикулин) или MPL (гомолог вирусного онкогена миелопролиферативной лейкемии).
Вторичным вследствие причин, не относящихся к костному мозгу, таких как хроническое аутоиммунное заболевание, либо как вторичный процесс, когда опухоль проникает в костный мозг.
Миелосклероз – это формирование дополнительной костной ткани, которое иногда сопровождает миелофиброз.
Миелоидная метаплазия, которая может сопровождать миелофтиз, независимо от его причины приводит к образованию экстрамедуллярных очагов кроветворения в печени, селезенке, лимфатических узлах.
Старый термин «идиопатическая миелоидная метаплазия» означает первичный миелофиброз с миелоидной метаплазией.
Этиология миелофтизной анемии
Наиболее распространенной причиной миелофтизной анемии является
Замещение костного мозга метастатическим раком
Наиболее частые виды рака в этом случае включают рак груди или предстательной железы; реже причиной являются рак почек, легких, надпочечников или щитовидной железы. Экстрамедуллярный гемопоэз, как правило, незначительный.
Снижение количества функциональной гемопоэтической ткани за счет инфильтрации костного мозга является основной причиной анемии.
Симптомы и признаки миелофтизной анемии
Миелоидная метаплазия может приводить к развитию спленомегалии, особенно у пациентов с болезнями накопления. В тяжелых случаях могут присутствовать симптомы анемии и основного заболевания. Массивная спленомегалия может вызывать чувство давления в области живота, раннее насыщение пищей, истощение, портальную гипертензию Портальная гипертензия Портальная гипертензия – повышенное давление в воротной вене. Наиболее частыми причинами этого состояния являются цирроз (в развитых странах), шистосоматоз (в эндемических областях) или сосудистые. Прочитайте дополнительные сведения и боли в левом верхнем квадранте живота; может наблюдаться гепатомегалия. Гепатоспленомегалия редко возникает при миелофиброзе, обусловленном злокачественными опухолями.
Диагностика миелофтизной анемии
Общий анализ крови (ОАК), эритроцитарные индексы, количество ретикулоцитов, мазок периферической крови
Исследование костного мозга
Миелофтизную анемию необходимо подозревать у пациентов с нормоцитарной анемией, особенно при наличии спленомегалии или возможного онкологического заболевания. При наличии подозрения на данную патологию необходимо выполнить мазок периферической крови Мазок периферической крови Анемия возникает при снижении числа эритроцитов (эритроциты измеряются количеством, гематокритом или содержанием гемоглобина в эритроцитах). У мужчин анемия определяется как уровень гемоглобина. Прочитайте дополнительные сведенияДанный тип анемии обычно характеризуется от умеренной до тяжелой степенью тяжести, нормоцитозом или незначительным макроцитозом. В морфологии эритроцитов может наблюдаться резкая вариабельность размера и формы (анизоцитоз и пойкилоцитоз). Количество лейкоцитов также может быть различным. Количество тромбоцитов часто снижено, они имеют большие размеры и неправильную форму.
Хотя исследование периферической крови может иметь важное значение, диагностика, как правило, основана на исследовании костного мозга Аспирация и биопсия костного мозга Анемия возникает при снижении числа эритроцитов (эритроциты измеряются количеством, гематокритом или содержанием гемоглобина в эритроцитах). У мужчин анемия определяется как уровень гемоглобина. Прочитайте дополнительные сведенияПри случайно выполненной рентгенографии можно обнаружить костные поражения (миелосклероз), характерные для длительно существующего миелофиброза, или другие костные изменения (остеобластические или литические поражения костей, обусловленные опухолью), указывающие на причину анемии.
Анемия при миелофтизе: причины, симптомы, диагностика, лечение
Весь контент iLive проверяется медицинскими экспертами, чтобы обеспечить максимально возможную точность и соответствие фактам.
У нас есть строгие правила по выбору источников информации и мы ссылаемся только на авторитетные сайты, академические исследовательские институты и, по возможности, доказанные медицинские исследования. Обратите внимание, что цифры в скобках ([1], [2] и т. д.) являются интерактивными ссылками на такие исследования.
Если вы считаете, что какой-либо из наших материалов является неточным, устаревшим или иным образом сомнительным, выберите его и нажмите Ctrl + Enter.
Анемия при миелофтизе является нормохромно-нормоцитарной и развивается при инфильтрации или замещении нормального пространства костного мозга негемопоэтическими или аномальными клетками. Причинами анемий являются опухоли, гранулематозные заболевания и болезни накопления липидов. Часто встречается фиброз костного мозга. Может развиваться спленомегалия. Характерными изменениями периферической крови являются анизоцитоз, пойкилоцитоз, наличие эритроцитарных и лейкоцитарных предшественников. Диагноз обычно требует проведения трепанобиопсии. Лечение состоит в поддерживающей терапии и устранении основного заболевания.
Описательная терминология, используемая при данном виде анемии, может запутать. Миелофиброз, при котором происходит замещение костного мозга фиброзной тканью, может быть идиопатическим (первичным) или вторичным. Истинный миелофиброз представляет собой аномалию стволовой клетки, при котором фиброз является вторичным по отношению к другим гемопоэтическим событиям. Миелосклероз представляет собой новое формирование костной ткани, которое иногда сопровождается миелофиброзом. Миелоидная метаплазия отражает наличие экстрамедуллярного гемопоэза в печени, селезенке или лимфоузлах и может сопровождаться миелофтизом, обусловленным другой причиной. Старый термин «идиопатическая миелоидная метаплазия» указывает на первичный миелофиброз с или без миелоидной метаплазии.
Код по МКБ-10
Причины анемии при миелофтизе
Наиболее частой причиной является замещение костного мозга метастазами злокачественной опухоли (чаще молочной железы или простаты, реже почек, легких, надпочечников или щитовидной железы); экстрамедуллярный гемопоэз не характерен. Среди других причин встречаются миелопролиферативные заболевания (особенно в поздних стадиях или прогрессирующая эритремия), гранулематозные болезни и болезни накопления (липидов). Миелофиброз может иметь место при всех вышеперечисленных случаях. У детей редкой причиной может быть болезнь Апьберс-Шенберга.
Миелоидная метаплазия может привести к спленомегалии, особенно у больных с болезнями накопления. Гепатоспленомегалия редко сочетается с миелофиброзом, обусловленным злокачественными опухолями.
Факторы риска
Факторами, способствующими уменьшению продукции эритроцитов, могут быть снижение числа функционирующих гемопоэтических клеток, метаболические нарушения, связанные с основным заболеванием, и в некоторых случаях эритрофагоцитоз. Экстрамедуллярный гемопоэз, или разрушение костномозговых полостей, вызывает высвобождение молодых клеток. Аномальные формы эритроцитов часто являются результатом повышенного разрушения эритроцитов.
Симптомы анемии при миелофтизе
В тяжелых случаях проявляются симптомы анемии и основного заболевания. Массивная спленомегалия может вызывать повышенное давление в брюшной полости, быстрое насыщение и боль в левом верхнем квадранте живота. Может присутствовать гепатомегалия.
Миелофтиз подозревается у больных с нормоцитарной анемией, особенно при наличии спленомегалии, если имеется потенциальное основное заболевание. При подозрении должен быть изучен мазок периферической крови, поскольку наличие незрелых миелоидных клеток и ядросодержащих эритроцитов, таких как нормобласты, предполагает наличие миелофтиза. Анемия обычно средней интенсивности, нормоцитарная, но может иметь тенденцию к макроцитозу. Морфология эритроцитов может демонстрировать крайние варианты в размерах и форме (анизоцитоз и пойкилоцитоз). Число лейкоцитов может варьировать. Число тромбоцитов чаще низкое, имеются гигантские, причудливой формы тромбоциты. Часто наблюдается ретикулоцитоз, который может быть обусловлен высвобождением ретикулоцитов из костного мозга или экстрамедуллярных зон и всегда указывает на регенерацию кроветворения.
Диагностика анемии при миелофтизе
Хотя исследование периферической крови может быть информативным, для диагноза необходимо изучение костного мозга. Показанием для пункции могут служить лейкоэритробластные изменения крови и необъяснимая спленомегалия. Получить аспират костного мозга часто бывает затруднительно, обычно требуется выполнение трепанобиопсии. Обнаруженные изменения зависят от основного заболевания. Эритропоэз нормален или в некоторых случаях усилен. Однако продолжительность жизни эритроцитов часто уменьшена. В селезенке или печени могут быть обнаружены очаги гемопоэза.
На рентгенографии костей скелета можно выявить костные изменения (миелосклероз), характерные для долговременного миелофиброза, или другие костные нарушения (остеобластные или литические очаги в костях), которые позволяют предположить причину анемии.
К кому обратиться?
Лечение анемии при миелофтизе
Лечение основного заболевания. В идиопатических случаях проводится поддерживающая терапия. Эритропоэтин (от 20 000 до 40 000 ЕД подкожно однократно или дважды в неделю), могут быть использованы глюкокортикоиды (например, преднизолон от 10 до 30 мг перорально ежедневно), однако, как правило, ответ незначительный. Гидроксимочевина (500 мг перорально ежедневно или через день) уменьшает размеры селезенки и приводит к нормализации уровней эритроцитов у многих больных, но для ответа требуется от 6 до 12 месяцев лечения. Талидомид (от 50 до 100 мг перорально ежедневно по вечерам) может дать умеренно выраженный ответ.
Анемия у пациентов с опухолевыми заболеваниями: от механизмов к диагностике и лечению
Анемия является частой находкой у людей с онкологическими заболеваниями. Её инцидентность у человека оценивается в широких пределах 30–70%, тогда как истинная частота встречаемости анемии у собак и кошек с опухолями не известна [1]. Как и у человека, наибольшая частота развития анемии отмечается у мелких домашних животных при наличии опухолей гематопоэтического происхождения (хронических и острых лейкозах, лимфомах, мастоцитомах, плазмаклеточных и гистиоцитарных опухолях), тогда как солидные опухоли реже сопровождаются анемией [2].
В ходе диагностики опухолей у мелких домашних животных выявление опухоль-ассоциированной анемии, определение её характера, выраженности и возможных причин играет важную роль по нескольким причинам. Во-первых, наличие выраженной анемии может потребовать коррекции перед началом лечения, направленного непосредственно на онкологическое заболевание, поскольку многие методы терапии злокачественных опухолей (хирургическое лечение, цитотоксическая химиотерапия, лучевая терапия) сопровождаются дополнительной потерей эритрона. Во-вторых, анемия может являться маркёром некоторых злокачественных опухолей (например, лейкозов), а также маркёром ответа данных опухолей на проводимую терапию. Таким образом, оценка динамики гематокрита/гемоглобина при проведении терапии может дать важную информацию об ответе на лечение. В-третьих, анемия является важным маркёром неблагоприятного прогноза для ряда опухолей. Например, в исследовании Miller A.G. с соавт. (2009) было показано, что собаки с лимфомой, сопровождающейся анемией, имели меньшую выживаемость при проведении лечения по сравнению с животными, имеющими нормальные показатели гематокрита [2].
Обзор данных литературы
Анемия у пациентов с онкологическими заболеваниями может возникать по различным причинам [3]:
- в результате непосредственного воздействия опухоли;
- в результате опосредованного влияния опухоли — как паранеопластический синдром;
- в ходе проведения противоопухолевого лечения.
Илл. 1.
А — гемоабдомен, развившийся у собаки в результате разрыва селезёнки (аутопсия);
Б — гемангиосаркома селезёнки собаки — крупное сосудистое злокачественное новообразование, часто приводящее к гемоабдомену в результате разрыва органа;
В — аутопсия кошки с метастазами фибросаркомы в лёгких, по плевре с формированием геморрагического плеврального выпота
Непосредственное воздействие опухоли может приводить к анемии по различным механизмам: 1) острая или хроническая кровопотеря; 2) гемолиз; 3) снижение продукции эритроцитов костным мозгом [3]. Так, наличие гемангиосарком селезёнки — злокачественных опухолей эндотелия кровеносных сосудов — часто сопровождается разрывом органа с накоплением гемоабдомена (илл. 1А, Б). И, наоборот, одной из самых частых причин развития геморрагического перитонеального выпота у собак является разрыв селезёнки с гемангиосаркомой [4]. При этом собаки могут поступать в клинику с симптомами острого геморрагического шока. При разрыве гемангиосарком селезёнки, а также печени цитологическое исследование редко является диагностичным для выявления опухолевых клеток, а основная терапия включает хирургическое удаление селезёнки/доли печени. Для корректировки анемии в данных случаях часто есть необходимость в проведении гемотрансфузий. Хроническая кровопотеря часто сопровождает эпителиальные опухоли слизистых оболочек — желудка и кишечника, носовых ходов (с развитием эпистаксиса), мочевого пузыря (с развитием геморрагического цистита), а также метастазирование любых злокачественных опухолей по серозным оболочкам с формированием геморрагических метастатических выпотных жидкостей (илл. 1В).
Гемолиз у онкологических пациентов может развиваться по иммуноопосредованным механизмам или в их отсутствие. Аутоиммунная гемолитическая анемия (АГА) развивается чаще всего при лейкозах и лимфомах у собак; у кошек лимфома, ассоциированная с вирусной лейкемией кошек, также может сопровождаться АГА [5]. В данном случае диагностичным будет проведение теста Кумбса на наличие антиэритроцитарных антител. У пациентов с АГА часто отмечается аутоагглютинация, а при исследовании мазка крови у собак часто могут быть выявлены сфероциты (мелкие эритроциты без центральной зоны просветления) (илл. 2А). В данных случаях основная терапия будет направлена на иммуносупрессию (преднизолон в дозировке 2–4 мг/кг в монотерапии и/или другие иммуносупрессанты) в течение длительного срока с постепенной отменой.
Илл. 2.
А — мазок крови со сфероцитами (мелкими эритроцитами без центральной зоны просветления), которые часто выявляют при аутоиммунной анемии;
Б — шистоциты — фрагментированные эритроциты, которые можно обнаружить у собак с гемангиосаркомой селезёнки при развитии микроангиопатического гемолиза;
В — мазок крови от кошки с гемолитической анемией с формированием телец Гейнца (Хайнца), окраска метиленовым синим (тельца имеют базофильную окраску, располагаются вблизи мембраны наподобие «соска») (А–В, окраска по Романовскому, ×1000)
Гемолиз в отсутствие иммуноопосредованных механизмов часто отмечают при гемангиосаркомах селезёнки в результате развития микроангиопатического гемолиза. При данной опухоли наличие большого сосудистого образования часто создаёт турбулентные потоки крови, проводящие к фрагментации эритроцитов с дальнейшим их внутрисосудистым гемолизом. В мазках крови в данном случае типично выявляют шистоциты (фрагментированные эритроциты) (илл. 2Б) [6]. Спленэктомия с возможной адъювантной химиотерапией (для профилактики развития гематогенных метастазов) показана у таких животных.
Другой причиной гемолиза может быть оксидативное повреждение эритроцитов с развитием анемии с тельцами Гейнца (Хайнца), которое описано у собак и кошек с лимфомой. Описано, что у кошек анатомическая форма алиментарной лимфомы (с локализацией в желудочно-кишечном тракте) наиболее часто приводит к анемии с тельцами Гейнца (илл. 2В) [3].
Редко встречающаяся опухоль селезёнки у собак — гемофагоцитарная гистиоцитарная саркома (злокачественная пролиферация CD11d+/CD18+ макрофаги красной пульпы селезёнки у собак) — сопровождается регенераторной гемолитической анемией, возникающей в результате активного фагоцитоза эритроцитов опухолевыми клетками. В связи с тем, что опухоль не даёт крупных очаговых образований, а сопровождается диффузной спленомегалией, её часто клинически путают с аутоиммунной гемолитической анемией и тромбоцитопенией. Для диагностики опухоли показана тонкоигольная аспирационная биопсия из селезёнки, которая имеет характерную цитологическую картину (илл. 3А). Основным лечением является спленэктомия, хотя прогноз заболевания даже при проведении хирургического лечения неблагоприятный в связи с высоким метастатическим потенциалом опухоли. По данным одного исследования, средняя выживаемость собак с опухолью составляет около семи недель (медиана — четыре недели) [7].
И, наконец, к прямому воздействию опухолей на костной мозг со снижением продукции эритроцитов относится миелофтиз — замещение костно-мозговых пространств клетками, подавляющими пролиферацию нормальных гематопоэтических клеток. При миелофтизе, характерном для лейкозов, диссеминированных лимфом (илл. 3В), мастоцитом (илл. 3Б), гистиоцитарных сарком и множественных миелом, реже — карцином и сарком, типично наличие нерегенераторной нормоцитарной нормохромной анемии средней или сильной степени, часто в сочетании с тромоцитопенией и лейкопенией [8]. При наличии таких изменений в клиническом анализе крови важнейшим этапом является оценка мазка венозной крови на наличие атипичных клеток (илл. 3Г). Для подтверждения миелофтиза необходимым также является цито- или гистологический анализ костного мозга (илл. 3Б, В).
Илл. 3.
А — цитологическая картина гемофагоцитарной гистиоцитарной саркомы селезёнки у собаки; в опухолевых клетках коричневые глыбчатые массы — кровяные пигменты из разрушенных эритроцитов;
Б — цитограмма костного мозга от собаки с диссеминированной мастоцитомой кожи с практически тотальным замещением костного мозга;
в центре и вверху — две гигантские клетки — мегакариоцита (предшественники тромбоцитов);
В — биоптат костного мозга от кошки с диссеминированной лимфомой — отмечается тотальное замещение костно-мозговых пространств крупными опухолевыми лимфоидными клетками (окраска гематоксилин-эозином, ×400);
Г — мазок крови от собаки с острым лимфоидным лейкозом из больших гранулярных лимфоцитов (А, Б, Г — окраска по Романовскому, ×1000)
При непрямом воздействии опухоли с развитием анемии имеют в виду паранеопластические синдромы (ПНС). Так, одним из часто развивающихся при мастоцитоме у собак ПНС является выброс гистамина опухоли с развитием гипергистаминемии, приводящей к язвам желудочно-кишечного тракта с развитием острой или хронической кровопотери. При развитии симптомов рвоты, анорексии, болезненности в области эпигастрия собакам с мастоцитомой показано назначение гастропротекторов (блокаторов гистаминовых рецепторов или протоновой помпы) [9]. К другому, редко встречающемуся ПНС относится гиперэстрогения при сертолиоме семенника с развитием аплазии костного мозга. Описано, что, несмотря на проведение кастрации, такие собаки с сертолиомой имеют неблагоприятный прогноз, поскольку костный мозг редко восстанавливается [10].
Ингибирование синтеза эритроцитов костным мозгом также возможно при дефиците нутриентов, таких как железо, витаминов В12 и фолиевой кислоты, которые могут развиваться при опухолях ЖКТ или при любых опухолях, сопровождающихся анорексией. Диагностика таких состояний и восполнение недостатка важных для эритропоэза нутриентов является важным для восстановления эритрона.
Анемия является частым осложнением противоопухолевого лечения у собак и кошек, прежде всего, при проведении цитотоксической химиотерапии. Анемия возникает как часть гематологического синдрома и категорируется у онкологических пациентов четырьмя степенями тяжести. Крайняя степень гематологических нарушений у собак и кошек при проведении противоопухолевого лечения встречается редко; чаще всего отмечается лёгкая или средняя степень нарушений, требующие минимальной поддержки. При развитии выраженной анемии показаны гемотрансфузии; для быстрого восстановления уровня эритроцитов может быть показано назначение эпокрина. Выявлять анемию необходимо в течение всего курса химиотерапии, поскольку её наличие может приводить к необходимости снижения дозировок, переносу или полной отмене следующего курса [11].
Заключение
В заключение необходимо отметить, что анемия является важным гематологическим отклонением, которое сопровождает целый ряд опухолей у мелких домашних животных. Выяснение лежащих в основе механизмов и определение степени выраженности анемии даёт ключ к пониманию подходов к её терапии. Кроме того, опухоль-ассоциированная анемия может быть важным неблагоприятным прогностическим фактором, что необходимо учитывать при планировании терапии, направленной на основное онкологическое заболевание.
Литература
1. Ludwig H., Van Belle S., Barrett-Lee P., Birgegrd G., et al. The European Cancer Anaemia Survey (ECAS): a large, multinational, prospective survey defining the prevalence, incidence, and treatment of anaemia in cancer patients. Eur J Cancer. 2004;40(15):2293–2306.
2. Miller A.G., Morley P.S., Rao S., Avery A.C., Lana S.E., Olver C.S. Anemia is associated with decreased survival time in dogs with lymphoma. J Vet Intern Med. 2009;23(1):116–122.
3. Childress M.O. Hematologic abnormalities in the small animal cancer patient. Vet Clin North Am Small Anim Pract. 2012;42(1):123–155.
4. Aronsohn M.G., Dubiel B., Roberts B., Powers B.E. Prognosis for acute nontraumatic hemoperitoneum in the dog: a retrospective analysis of 60 cases (2003–2006). J Am Anim Hosp Assoc. 2009;45(2):72–77.
5. Kohn B., Weingart C., Eckmann V., Ottenjann M., Leibold W. Primary immune-mediated hemolytic anemia in 19 cats: diagnosis, therapy, and outcome (1998–2004). J Vet Intern Med. 2006;20(1):159–166.
6. Hammer A.S., Couto C.G., Swardson C., Getzy D. Hemostatic abnormalities in dogs with hemangiosarcoma. J Vet Intern Med. 1991;5(1):11–14.
7. Moore P.F., Affolter V.K., Vernau W. (2006) Canine hemophagocytic histiocytic sarcoma: a proliferative disorder of CD11d macrophages. Vet Pathol. 43(5):632–645.
8. Marconato L., Bettini G., Giacoboni C., Romanelli G., Cesari A., Zatelli A., Zini E. Clinicopathological features and outcome for dogs with mast cell tumors and bone marrow involvement. J Vet Intern Med. 2008;22(4):1001–1007.
9. Blackwood L., Murphy S., Buracco P., De Vos J.P., De Fornel-Thibaud P., et al. European consensus document on mast cell tumours in dogs and cats. Vet Comp Oncol. 2012;10(3):e1–e29.
10. Sanpera N., Masot N., Janer M., Romeo C., de Pedro R. Oestrogen-induced bone marrow aplasia in a dog with a Sertoli cell tumour. J Small Anim Pract. 2002;43(8):365–9.
11. Rizzo J.D., Brouwers M., Hurley P., et al. American Society of Clinical Oncology/American Society of Hematology clinical practice guideline update on the use of epoetin and darbepoetin in adult patients with cancer. J Clin Oncol 2010;33:4996–5010.
Диагностика и лечение хронической аутоиммунной гемолитической анемии
Больная Ш., 80 лет, пенсионерка. Из анамнеза известно, что в течение последних двух лет неоднократно проходила амбулаторное и стационарное лечение по поводу хронической B12–фолиеводефицитной анемии, диагностированной на основании анемического синдрома в сочетании с гиперхромией и макроцитозом эритроцитов. Стернальная пункция, определение уровня витамина B12 и фолиевой кислоты не проводились. Отмечался временный незначительный положительный эффект лечения витамином B12. С конца 2011 года, несмотря на ежемесячное введение витамина B12 в дозе 500γ в сочетании с фолиевой кислотой, стала нарастать анемия (14.02.2012 г. гемоглобин – 54 г/л). Для обследования и лечения госпитализирована в больницу № 40 с диагнозом: B12–фолиеводефицитная анемия тяжелой степени. ИБС. Стенокардия напряжения II ф. к. Гипертоническая болезнь II ст. Желчнокаменная болезнь. Хронический калькулезный холецистит. Мочекаменная болезнь. Конкремент правой почки, простые кисты обеих почек. Полипы желудка.
При поступлении жалобы на выраженную общую слабость, головокружения, головную боль, учащенное сердцебиение, перебои в работе сердца.
При объективном осмотре отмечены субиктеричность кожи и слизистых оболочек, умеренная гепатомегалия (+2 см) и спленомегалия (+ 2 см).
Результаты клинического анализа в динамике представлены в таблице 1.
Таблица 1. Клинические анализы крови пациентки Ш. в динамике
| 15.02.12 | 54 | 1.39 | 10.5 | 133 | 80 | 2 | 66 | 21 | 9 | 2 | - | 75 |
| 11.03.12 | 50 | 1.41 | 11.8 | 114 | 98 | 4 | 75 | 11 | 4 | 3 | 1 | 78 |
| 15.03.12 | 49 | 1.31 | 17.8 | 121 | 288 | 4* | 60 | 23 | 5 | 1 | - | 78 |
| 20.03.12 | 72 | 1.93 | 11.4 | 116 | 297 | 2 | 73 | 14 | 7 | 2 | 0 | 46 |
| 27.03.12 | 66 | 1.9 | 11 | 108 | 202 | 2 | 60 | 26 | 7 | 3 | 0 | 40 |
| 12.04.12 | 70 | 1.75 | 1.9 | 112 | 104 | 3 | 62 | 24 | 11 | 0 | 0 | 27 |
| 26.04.12 | 93 | 2.56 | 5.7 | 109 | 148 | 3 | 74 | 13 | 9 | 0 | 0 | 11 |
| 24.06.12 | 111 | 3.42 | 4.7 | 97 | 7 | 2 | 69 | 21 | 10 | 0 | 1 | 15 |
| 16.08.12 | 120 | 3.97 | 5.8 | 93 | 12 | - | 71 | 19 | 9 | 1 | 0 | 40 |
Примечание: * в лейкоцитарной формуле 15.03.12 выявлялись также миелоциты (2%) и метамиелоциты (5%).
При поступлении выявлены гиперхромная анемия (гемоглобин 54 г/л, эритроциты 1,39×10 12 /л , MCV 133 фл), ретикулоцитоз (80‰), ускорение СОЭ (75 мм/час), анизоцитоз, пойкилоцитоз и анизохромия эритроцитов.
В биохимическом анализе крови – повышение уровня креатинина (189 ммоль/л), билирубина (58 ммоль/л) за счет непрямого билирубина.
УЗИ органов брюшной полости: гепатоспленомегалия; камни желчного пузыря; диффузные изменения поджелудочной железы; простые кисты обеих почек, конкремент правой почки.
ФГДС: два полипа желудка размером до 0,5 см.
Учитывая высокий риск сердечно-сосудистых осложнений у пожилой пациентки с анемией тяжелой степени, проведены трансфузии эритроцитарной взвеси. На основании клинико-лабораторных данных (спленомегалия, гипербилирубинемия, гиперхромная анемия с ретикулоцитозом) и неэффективности лечения витамином B12 и фолиевой кислотой заподозрена гемолитическая анемия.
При исследовании крови на антиэритроцитарные антитела выявлены аутоантитела класса IgG ++++.
Результаты стернальной пункции представлены в таблице 2.
Таблица 2.Миелограмма пациентки Ш. от 17.02.12 г.
Заключение
Клеточный костномозговой пунктат. Эритропоэз – нормобластический. Гиперплазия эритроидного ростка – 74,8%. Со стороны эритрокариоцитов отмечаются клетки с цитоплазматическими мостиками, скопления в виде «эритроидных островков».
Мегакариоциты различной степени зрелости с умеренным тромбоцитообразованием.
На основании данных миелограммы (гиперплазия эритроидного ростка при нормобластическом типе кроветворения) и выявления антиэритроцитарных антител диагностирована аутоимунная гемолитическая анемия с тепловыми антителами. При дополнительном обследовании признаков вторичного характера анемии не выявлено.
С 11.03.12 г. начата пульс-терапия метипреднизолоном в дозе 500 мг 1 раз в день внутривенно в сочетании с пероральным приемом преднизолона в дозе 45 мг в сутки под прикрытием гастропротекторов. После 5 дней лечения анемический синдром продолжал нарастать, появился выраженный сдвиг лейкоцитарной формулы влево, увеличение количества ретикулоцитов (табл.1). Доза преднизолона перорально увеличена до 75 мг в сутки, к лечению добавлен азатиоприн по 100 мг/сутки per os, проведена трансфузия1 дозы эритроцитарной взвеси.
С 20.03.12 г. с учетом сохраняющегося гемолиза (ретикулоциты 297‰) проведен второй курс пульс-терапии метилпреднизолоном в дозе 500 мг в сутки № 4, однократно введен внутривенно циклофосфан в дозе 600 мг.
Лечение больная переносила хорошо. С 27.03.12 г. отмечена тенденция к увеличению уровня гемоглобина без поддерживающих гемотрансфузий. Решено продолжить введение циклофосфана по 200 мг в сутки, отменить азатиоприн. Анемический синдром продолжал уменьшаться: к 12.04.12 г. уровень гемоглобина достиг 70 г/л, снизился гемолиз (ретикулоцитов 104‰), однако развилась лейкопения (1,9×10 9 /л), в связи с чем циклофосфан был временно отменен. После восстановления количества лейкоцитов лечение циклофосфаном по 200 мг дважды в неделю было возобновлено на фоне постепенного снижения дозы преднизолона.
Больная в удовлетворительном состоянии 28.04.12 г. выписана из стационара. На амбулаторном этапе продолжено введение циклофосфана по 200 мг в сутки 2 раза в неделю, преднизолон в течение месяца полностью отменен.
В течение нескольких месяцев получала поддерживающую терапию циклофосфаном по 200 мг в сутки 2 раза в неделю (суммарная доза составила 7200 мг). На этом фоне уровень гемоглобина стабилен в пределах 100–120 г/л, количество ретикулоцитов не превышает 20%.
Комментарий к клиническому случаю
Аутоиммунная гемолитическая анемия (АИГА) – гетерогенная группа заболеваний и синдромов, обусловленных повышенным разрушением эритроцитов вследствие образования аутоантител. Частота АИГА во всех возрастных группах составляет 1:40000 – 1:80000, причем женщины болеют в 2 раза чаще мужчин. Выделяют первичные (идиопатические) и вторичные АИГА, которые чаще всего развиваются при лимфомах, солидных опухолях и заболеваниях соединительной ткани. По серологическим свойствам различают АИГА с тепловыми (85%) и холодовыми (15%) антителами; по месту разрушения эритроцитов выделяют АИГА с внутриклеточным (наиболее частым), внутрисосудистым и смешанным гемолизом.
Клинические проявления АИГА:
- анемия;
- иктеричность кожи и склер;
- умеренная спленомегалия;
- субфебрильная температура тела.
При внутрисосудистом гемолизе моча приобретает темно-бурую или черную окраску.
Лабораторные критерии:
- анемия с высоким ретикулоцитозом;
- повышение уровня билирубина за счет непрямого;
- наличие антиэритроцитарных антител (при холодовой форме часто не выявляются);
- гиперплазия эритроидного ростка костного мозга.
Стандарт первой линии терапии АИГА – пероральные глюкокортикостероиды в начальной дозе 1 мг/кг в сутки, возможно проведение пульс-терапии метилпреднизолоном в дозе 0,5–1,0 г/сутки внутривенно в течение 3-5 дней. Второй линией терапии является спленэктомия, которая используется при отсутствии эффекта глюкокортикостероидов в течение 4–6 месяцев. У пожилых пациентов показано назначение иммунодепрессивных и цитостатических препаратов (азатипоприн, циклофосфон, циклоспорин). Значительно реже используют моноклональные антитела (ритуксимаб) и иммуноглобулин. Выживаемость больных АИГА в течение 5 лет составляет 75%.
При анализе данного случая обращает внимание длительное латентное течение заболевания у больной преклонного возраста с гиперхромной анемией, что послужило причиной ошибочного диагноза B12–дефицитной анемии (для АИГА характерен нормохромный характер анемии). С учетом возраста пациентки и наличия сопутствующих заболеваний было принято решение о подключении к лечению цитостатической терапии, позволившее получить ремиссию заболевания, отменить глюкокортикостероиды и отказаться от проведения спленэктомии.
Читайте также:
